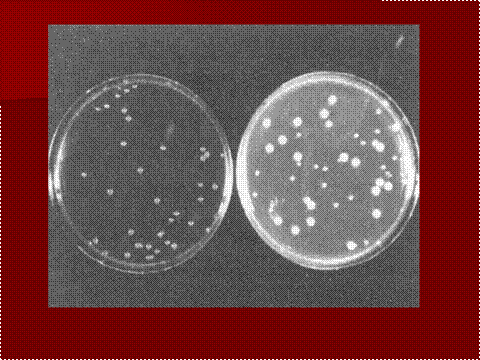

Definitii:
DECONTAMINARE: reducerea numarului de germeni de pe un obiect sau dintr-o substanta
ANTISEPSIE: decontaminarea tegumentelor si mucoaselor cu ajutorul unor substante chimice antiseptice bacteriostatice (netoxice pentru tegument): alcool etilic 70 , tinctura de iod 5%, KMnO 0,1%, detergenti cationici.
DEZINFECTIE: distrugerea patogenilor (mai putin a sporilor) de pe suprafete, din aer, cu
ajutorul unor substante chimice dezinfectante bactericide (toxice pentru tesuturi vii): fenoli,
formol, H CO . Impiedica raspandirea bolilor infectioase.
STERILIZARE: distrugerea sau indepartarea tuturor formelor vii (inclusiv spori)
ASEPSIE: absenta patogenilor mentinerea sterilitatii presupune aplicarea tehnicilor aseptice pentru a impiedica patrunderea microbilor intr-un substrat steril.
PREZERVARE, CONSERVARE - pastrarea viabilitatii microorganismelor o durata variabila de timp
CURAT lipsit de murdarie organica/anorganica (fara referire la microorganisme)
Metode fizice
I. Caldura
a. Caldura uscata
Incalzirea la rosu ansa de platina

Flambare completarea sterilizarii trecerea obiectului prin flacara
Incinerarea arderea cu reducere la cenusa
indicatii: materiale dispozabile din plastic, reziduuri organice solide,
carcasele, cadavrele animalelor
Sterilizarea prin aer cald mecanism de actiune: oxidare
indicatii: sticlarie de laborator, vase din portelan, instrumentar
chirurgical, pulberi termostabile
contraindicatii: solutii apoase, obiecte din cauciuc, plastic, tesaturi
si vata din bumbac sau fibra sintetica, materialele contaminate din
laborator
se realizeaza in etuva (cuptorul Pasteur, Poupinel)
C 2h, 180 C 1h

b. Caldura umeda
Fierberea mecanism de actiune: denaturare
distruge formele vegetative, nu si sporii
nu este metoda de sterilizare eficienta
C, 30 minute
Tindalizarea sterilizarea fractionata: evita incalzirea la temperaturi de
peste100 C
incalzire in 3 zile consecutive, intre incalziri incubare la termostat
pentru germinarea sporilor
tindalizare
la 100 C in vasul Koch (
tindalizare la 65 C in baie de apa
sterilizarea unor medii de cultura, alimente
Sterilizare prin vapori sub presiune autoclavarea; mecanism de actiune:
denaturare
temperatura vaporilor de apa intr-un spatiu inchis creste proportional
cu presiunea
0,5 atm 115 C
1 atm 121 C
2 atm 134 C
in microbiologie: 121 C timp de 15- 30
in blocurile operatorii: 134 C timp de 30
indicatii: sterilizarea materialului infectios din laborator, medii de
cultura termostabile, instrumente chirurgicale, halate, campuri
operatorii, etc.
contraindicatii: material plastic, piele, blana

II. Pasteurizarea
denaturarea proteinelor expunere la temperaturi de sub 100 C
produse alimentare termolabile
nu se distrug: micobacteriile, enterovirusurile
- joasa (LTLT low temperature long time)
- inalta (HTST high temperature short time)
- (UHT ultra high temperature)

III. Filtrarea
retinerea microorganismelor din medii lichide sau aer
trecerea prin membrane cu porozitati diferite (0,22m m m
membrane: acetat, nitrat celuloza, policarbonat, teflon
sterilizarea lichidelor termolabile si sterilizarea aerului pentru crearea unui
mediu aseptic (boxe cu flux de aer laminar HEPA filter: High-efficiency
Particulate Air)
IV. Radiatii
ionizante distrug ADN-ul
- penetratie mare
- sterilizarea instrumentelor chirurgicale, stomatologice
- nu este o metoda des folosita
neionizante alterarea ADN-ului
- ex. razele UV lampa germicida
- nu sunt penetrante
- sterilizarea suprafetelor de lucru netede, curate, sanitizarea
saloanelor, salilor de operatie

V. Vibratii ultrasonice
I. Agentii alkilanti
au actiune sporo- si bactericida (glutaraldehida, oxidul de etilen); formaldehida
are doar efect dezinfectant
sterilizarea instrumentelor medicale, a echipamentelor endoscopice, a
medicamentelor
oxidul de etilen: substanta gazoasa cu penetrabilitate mare
glutaraldehida: solutie apoasa
II. Solutii dezinfectante si antiseptice
Halogenii
- Clorul si derivatii de clor, hipocloritii
- Iodoforii
Derivatii fenolici
Detergenti
Alcooli etanol 70-80%
Substante chimice utilizate in microbiologie:
- pentru dezinfectie: cloramina 5%, fenol 3%, etc.
- pentru antisepsia mainilor: bromocet 1%o, cloramina 1%, etc.
Metode de prezervare
1. Frigul
refrigerare: 4 C: stare de viata latenta efect bactriostatic
congelare la -21 C sterilizare
congelare brusca la -70 C: prezervare
2. Desicare
liofilizarea congelare brusca si desicare: prezervarea pe termen lung a
culturilor bacteriene,
presiune osmotica indepartarea apei din alimente (fructe, lapte praf)
Controlul sterilizarii si al sterilitatii
Controlul sterilizarii: controlul procesului de sterilizare
metode fizice controlul temperaturii (termometru), presiunii (manometru), timpului de expunere
metode chimice: se folosesc substante cu punct de fuziune apropiat de temperatura la
care se face sterilizarea (acidul benzoic are punctul de fuziune la temperatura de 121 C)

atingerea temperaturii de 121 C duce la distrugerea sporilor, indicatorul din fiole
vireaza

Controlul sterilitatii: eficienta sterilizarii si mentinerea sterilitatii; se realizeaza prin metode
bacteriologice (recoltarea probelor de pe suprafete sterile, cultivare)

Pentru asigurarea feed-back-ului si evaluarea performantelor se vor face aplicatii practice in
laboratorul de microbiologie.
Se va observa modul de functionare a aparaturi de laborator implicata in sterilizare.
Se va arata un control al calitatii sterilizarii.
|